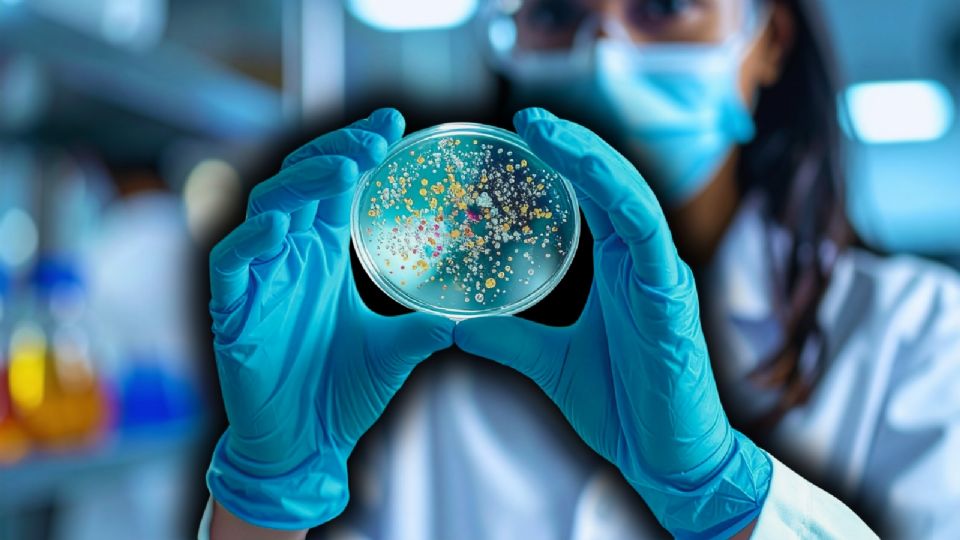

Recientemente, la comunidad científica internacional analiza cómo una superbacteria milenaria en el hielo fue extraída de una profunda caverna.
Este ecosistema, conocido por sus condiciones extremas de frío y total aislamiento, ha funcionado como una cápsula del tiempo biológica, preservando secretos que podrían cambiar nuestra comprensión sobre la evolución de la vida y la efectividad de los medicamentos actuales.
Foto: Canva
Un enigma de 5 mil años oculto en Scarisoara
En la cueva de hielo de Scarisoara, en Rumania, un equipo de investigadores logró aislar la cepa denominada Psychrobacter SC65A.3. Este microorganismo fue hallado en una capa de hielo datada en aproximadamente 5 mil años de antigüedad.
Te podría interesar
Lo que hace que este descubrimiento sea verdaderamente impactante no es solo su supervivencia a temperaturas gélidas, sino su capacidad de resistir a fármacos que ni siquiera existían cuando este organismo quedó atrapado en la helada perpetua de la caverna.
Resistencia extrema: 10 antibióticos desafiados por la superbacteria milenaria en el hielo
Lo verdaderamente interesante del estudio reside en el perfil de resistencia de este espécimen. Los análisis revelaron que el microorganismo posee una resistencia multidrogas (MDR) ante 10 antibióticos distintos pertenecientes a 8 clases diferentes. Entre ellos destacan las cefalosporinas de tercera generación, fluoroquinolonas, aminoglucósidos y la rifampicina.
Te podría interesar
Según los expertos, el genoma de esta superbacteria milenaria en el hielo contiene más de 100 genes asociados a la resistencia antimicrobiana, lo que demuestra que este fenómeno es una característica natural del ecosistema que evolucionó mucho antes del uso clínico de fármacos en humanos.
El legado de Paun y Purcarea en la microbiología moderna
Este estudio, publicado originalmente en la revista Frontiers in Microbiology por los autores Victoria Ioana Paun, Corina Itcus, Paris Lavin, Mariana Carmen Chifiriuc y Cristina Purcarea, resalta que estos depósitos de nieve y hielo antiguos son reservorios inexplorados de "resistomas".
Foto: Canva
Además de su resistencia, la bacteria mostró una dualidad fascinante: es capaz de inhibir a 14 patógenos del grupo ESKAPE, lo que abre la puerta a nuevas aplicaciones biotecnológicas. Entender a la superbacteria milenaria en el hielo es, en última instancia, fundamental para prepararnos ante los desafíos médicos globales del futuro.